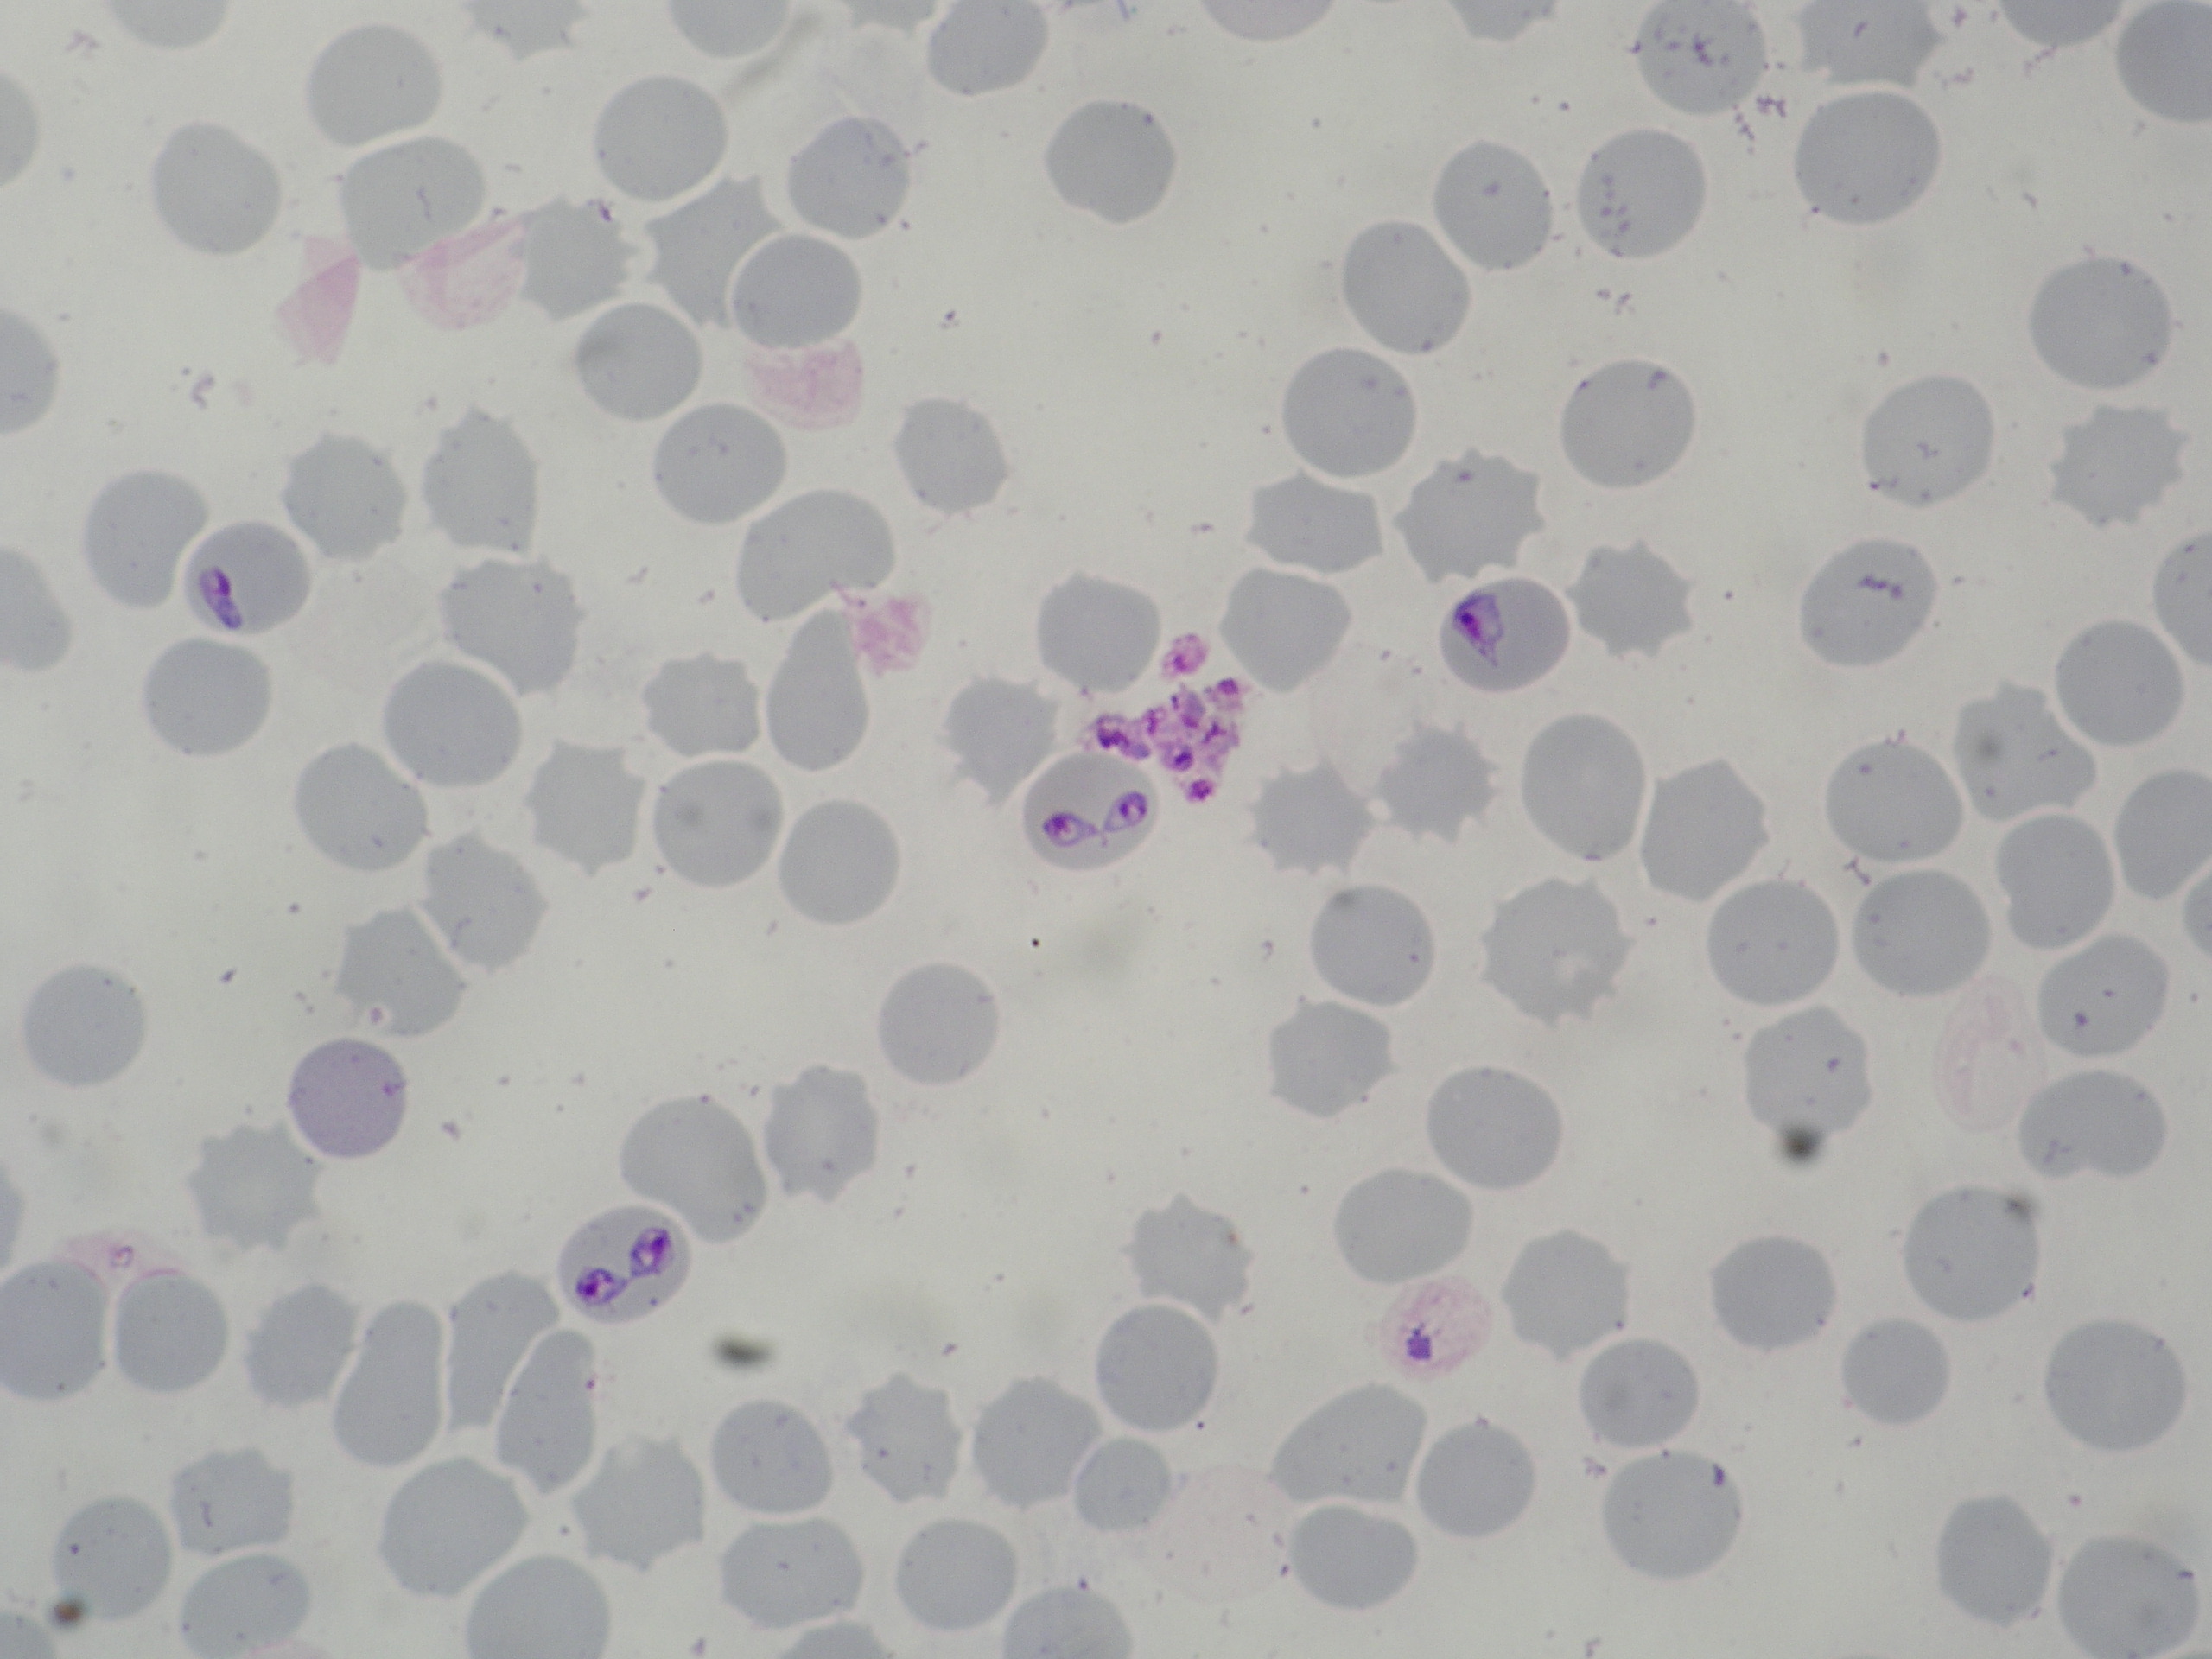
Babesiose hos hund en ny diagnose i Danmark Dansk Veterinærtidsskrift

procox hund puzzle hund prednisolon hund morgens oder abends previcox hund kaufen prada hund protestpinkler hund quoka hunde bayern prednisolon dosierung hund puls messen hund prozessionsspinner hund

Urlaub im Süden Risiko für den Hund? From bestehunde.de
Der wirkstoff von carbesia ®, imidocarb ist ein substituiertes carbanilid, das als antiprotozoikum zur bekämpfung von babesia ssp.
Es wird grundsätzlich die subkutane injektion empfohlen. Imidocarb ist ein in der veterinärmedizin eingesetzter arzneistoff zur therapie und prophylaxe von babesiosen bei hunden, pferden und rindern. For example, it is used to. Imizol (imidocarb dipropionate) is a sterile solution containing 120 mg/ml of imidocarb dipropionate suitable for intramuscular or subcutaneous administration. The complex chemical structure has been. Imidocarb là một dẫn xuất urê được sử dụng trong thú y như là một chất chống độc tố để điều trị nhiễm trùng babesia và các ký sinh trùng khác. Imidocarb is used to treat babesiosis and a strain of canine ehrlichiosis called e. Imidocarb summary report (1) 1. Es wird grundsätzlich die subkutane injektion empfohlen (steuber 1999a), da diese besser toleriert wird (elias 1988a).rind:
tierheim stuttgart hunde klein tierheim stade hunde tierheim pfungstadt hunde tierheim stralsund hunde tierheim mönchengladbach hunde welpen tierheim remagen hunde tierheim pirmasens hunde tierheim neunkirchen hunde tierheim remscheid hunde tierheim lohr hunde

Source: dvt.ddd.dk
It exerts its action through two mechanisms i) interference with the production and/or utilization of polyamines, ii) prevention of entry of inositol into the erythrocyte containing the parasite. This drug entry is a stub and has not been fully annotated. Imidocarb is a carbanilide compound. These animals, amongst which are the common. The complex chemical structure has been. Imidocarb free base residues in tissues of cattle which received a single injection (sc) of imidocarb at 3.0 mg/kg bodyweight.1 withdrawal mean recovery corrected imidocarb.
Babesiose hos hund en ny diagnose i Danmark Dansk Veterinærtidsskrift

Source: de.pestctrl.biz
Imidocarb summary report (1) 1. Imidocarb dipropionate is highly active against infections caused by adult and immature stages of. For example, it is used to. Über den wirkungsmechanismus ist nur wenig. One of 13 healthy dogs used in a pharmacokinetic study of imidocarb dipropionate died due to difficulty in breathing, tachycardia, weakness and profuse diarrhoea. Es wird grundsätzlich die subkutane injektion empfohlen.
Piroplasmose bei Hunden Symptome und Behandlung zu Hause

Source: de.pestctrl.biz
This drug entry is a stub and has not been fully annotated. Imidocarb is a carbanilide compound. Es wird grundsätzlich die subkutane injektion empfohlen. Imidocarb is used to treat babesiosis and a strain of canine ehrlichiosis called e. It exerts its action through two mechanisms i) interference with the production and/or utilization of polyamines, ii) prevention of entry of inositol into the erythrocyte containing the parasite. Imidocarb free base residues in tissues of cattle which received a single injection (sc) of imidocarb at 3.0 mg/kg bodyweight.1 withdrawal mean recovery corrected imidocarb.
Was tun, wenn ein Hund von einer Zecke gebissen wird?

Source: www.zooplus.de
Imidocarb ist ein in der veterinärmedizin eingesetzter arzneistoff zur therapie und prophylaxe von babesiosen bei hunden, pferden und rindern. Imizol (imidocarb dipropionate) is a sterile solution containing 120 mg/ml of imidocarb dipropionate suitable for intramuscular or subcutaneous administration. Imidocarb is a carbanilide compound. Eliminates the issue of treatment compliance. Imidocarb free base residues in tissues of cattle which received a single injection (sc) of imidocarb at 3.0 mg/kg bodyweight.1 withdrawal mean recovery corrected imidocarb. Der wirkstoff von carbesia ®, imidocarb ist ein substituiertes carbanilid, das als antiprotozoikum zur bekämpfung von babesia ssp.
Anaplasmose beim Hund Symptome & Behandlung zooplus

Source: www.zooplus.de
Eliminates the issue of treatment compliance. Über den wirkungsmechanismus ist nur wenig. It is scheduled to be annotated soon. Imidocarb diprobionate 85 mg/ml, injectable, babesiosis treatment. Imidocarb is a carbanilide compound. For example, it is used to.
Anaplasmose beim Hund Symptome & Behandlung zooplus

Source: de.pestctrl.biz
Imidocarb summary report (1) 1. Imidocarb has been used traditionally to treat ehrlichia canis ehrlichia canis in combination with doxycycline doxycycline. In veterinary medicine it is.
Was tun, wenn ein Hund von einer Zecke gebissen wird?

Source: www.pfotenprinz.eu
It may cause colic, hypersalivation, diarrhea and/or death. Imidocarb 4.25 mg per kg body weight corresponding to 0.5 ml per 10 kg bodyweight. Eliminates the issue of treatment compliance.
Urlaubskrankheiten beim Hund Pfotenprinz

Source: www.esccap.de
Imidocarb 4.25 mg per kg body weight corresponding to 0.5 ml per 10 kg bodyweight. It is scheduled to be annotated soon. Eliminates the issue of treatment compliance.
VBDs ESCCAP DEUTSCHLAND

Source: www.zooplus.de
Injectable administration keeps the treatment under your control. For example, it is used to. Über den wirkungsmechanismus ist nur wenig.
Anaplasmose beim Hund Symptome & Behandlung zooplus

Source: bestehunde.de
Imidocarb 4.25 mg per kg body weight corresponding to 0.5 ml per 10 kg bodyweight. It is scheduled to be annotated soon. References this page was last edited.
Urlaub im Süden Risiko für den Hund?

Source: bestehunde.de
Imidocarb is a urea derivative used in veterinary medicine as an antiprotozoal agent for the treatment of infection with babesia and other parasites. The complex chemical structure has been. Imidocarb ist ein in der veterinärmedizin eingesetzter arzneistoff zur therapie und prophylaxe von babesiosen bei hunden, pferden und rindern.
Urlaub im Süden Risiko für den Hund?

Source: bestehunde.de
Imidocarb is a carbanilide derivative with antiprotozoal activity. This drug entry is a stub and has not been fully annotated. Trypan blue is an antiprotozoal drug first used to treat babesia infection in 1909 and still commonly used to treat babesia canis.
Urlaub im Süden Risiko für den Hund?

Source: www.pfotenprinz.eu
It prevents access of protozoal parasites to inositol and also produces vacuolization and deformation of cytoplasmic structure, ending in blood. Canis, both of which are types of parasitic infections. Eliminates the issue of treatment compliance.
Urlaubskrankheiten beim Hund Pfotenprinz

Source: bestehunde.de
Imidocarb is a toxic drug and should be used with care. This drug entry is a stub and has not been fully annotated. Imidocarb là một dẫn xuất urê được sử dụng trong thú y như là một chất chống độc tố để điều trị nhiễm trùng babesia và các ký sinh trùng khác.
Urlaub im Süden Risiko für den Hund?

Source: bestehunde.de
In veterinary medicine it is. Eliminates the issue of treatment compliance. These animals, amongst which are the common.
Urlaub im Süden Risiko für den Hund?
Source: dvt.ddd.dk
Imidocarb is a toxic drug and should be used with care. One of 13 healthy dogs used in a pharmacokinetic study of imidocarb dipropionate died due to difficulty in breathing, tachycardia, weakness and profuse diarrhoea. Imidocarb is a carbanilide derivative with antiprotozoal activity.
Babesiose hos hund en ny diagnose i Danmark Dansk Veterinærtidsskrift

Source: bestehunde.de
References this page was last edited. It exerts its action through two mechanisms i) interference with the production and/or utilization of polyamines, ii) prevention of entry of inositol into the erythrocyte containing the parasite. Imidocarb 4.25 mg per kg body weight corresponding to 0.5 ml per 10 kg bodyweight.
Urlaub im Süden Risiko für den Hund?

Source: bestehunde.de
Imidocarb is a toxic drug and should be used with care. Imidocarb has been used traditionally to treat ehrlichia canis ehrlichia canis in combination with doxycycline doxycycline. Imidocarb summary report (1) 1.
Urlaub im Süden Risiko für den Hund?

Source: www.gesundheitszentrum-fuer-kleintiere-luedinghausen.de
Treatment and prevention of babesiosis in cattle, sheep, horses, donkeys, mules. One of 13 healthy dogs used in a pharmacokinetic study of imidocarb dipropionate died due to difficulty in breathing, tachycardia, weakness and profuse diarrhoea. Imizol (imidocarb dipropionate) is a sterile solution containing 120 mg/ml of imidocarb dipropionate suitable for intramuscular or subcutaneous administration.
Babesiose bei Hunden Gesundheitszentrum für Kleintiere

Source: bestehunde.de
References this page was last edited. For example, it is used to. Imidocarb is a toxic drug and should be used with care.
Urlaub im Süden Risiko für den Hund?

Source: www.gesundheitszentrum-fuer-kleintiere-luedinghausen.de
Imidocarb is a carbanilide compound. Imidocarb is a carbanilide derivative with antiprotozoal activity. Imidocarb summary report (1) 1.
Babesiose bei Hunden Gesundheitszentrum für Kleintiere

Source: deinetiere.com
Es wird grundsätzlich die subkutane injektion empfohlen (steuber 1999a), da diese besser toleriert wird (elias 1988a).rind: The complex chemical structure has been. Imizol (imidocarb dipropionate) is a sterile solution containing 120 mg/ml of imidocarb dipropionate suitable for intramuscular or subcutaneous administration.
Borreliose Diagnose und Vorbeugung Deine Tiere

Source: de.pestctrl.biz
Canis, both of which are types of parasitic infections. Eliminates the issue of treatment compliance. Imidocarb free base residues in tissues of cattle which received a single injection (sc) of imidocarb at 3.0 mg/kg bodyweight.1 withdrawal mean recovery corrected imidocarb.
Piroplasmose bei Hunden Symptome und Behandlung zu Hause

Source: www.gesundheitszentrum-fuer-kleintiere-luedinghausen.de
Eliminates the issue of treatment compliance. Imidocarb summary report (1) 1. Imidocarb ist ein in der veterinärmedizin eingesetzter arzneistoff zur therapie und prophylaxe von babesiosen bei hunden, pferden und rindern.
Babesiose bei Hunden Gesundheitszentrum für Kleintiere

Source: www.zooplus.de
Der wirkstoff von carbesia ®, imidocarb ist ein substituiertes carbanilid, das als antiprotozoikum zur bekämpfung von babesia ssp. It is scheduled to be annotated soon. Imidocarb ist ein in der veterinärmedizin eingesetzter arzneistoff zur therapie und prophylaxe von babesiosen bei hunden, pferden und rindern.
Anaplasmose beim Hund Symptome & Behandlung zooplus

Source: www.gesundheitszentrum-fuer-kleintiere-luedinghausen.de
Treatment and prevention of babesiosis in cattle, sheep, horses, donkeys, mules. Der wirkstoff von carbesia ®, imidocarb ist ein substituiertes carbanilid, das als antiprotozoikum zur bekämpfung von babesia ssp. Imidocarb dipropionate 120 mg description:
Babesiose bei Hunden Gesundheitszentrum für Kleintiere

Source: www.pfotenprinz.eu
Imidocarb is a urea derivative used in veterinary medicine as an antiprotozoal agent for the treatment of infection with babesia and other parasites. Imidocarb dipropionate 120 mg description: Imidocarb là một dẫn xuất urê được sử dụng trong thú y như là một chất chống độc tố để điều trị nhiễm trùng babesia và các ký sinh trùng khác.


